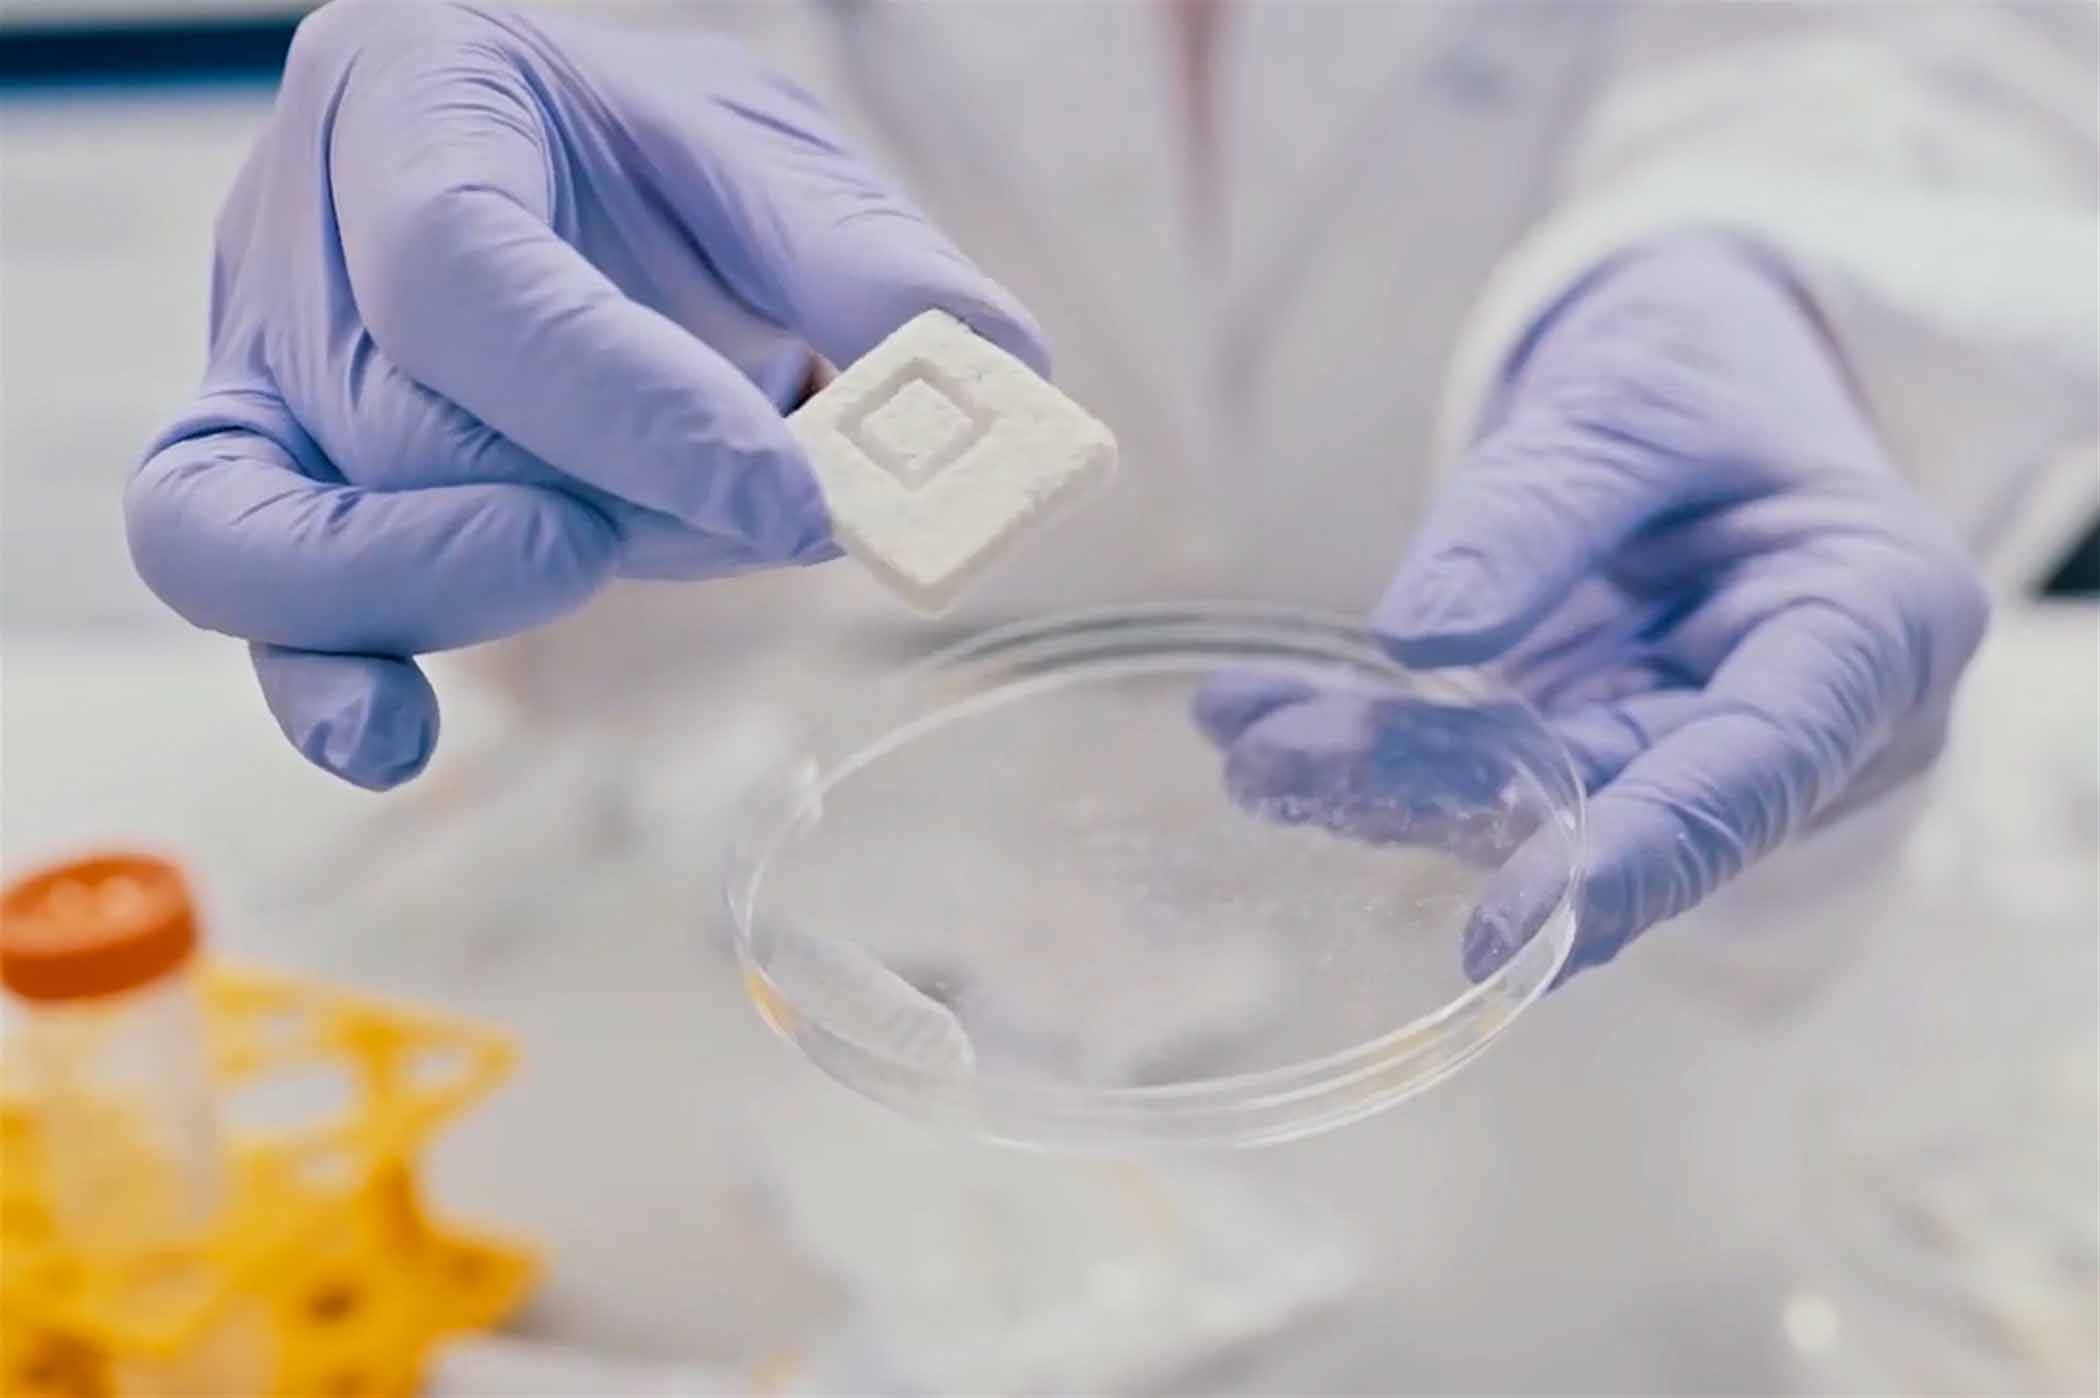

COM_SUCCESSES_DETAIL_PROJECT_DESCRIPTION

Realizacja projektu dotyczyła stworzenia linii do produkcji kompozytu bioaktywnego FlexiOss w warunkach laboratoryjnych.
Pomysłodawcą tzw. „sztucznej kości” jest prof. dr hab. Grażyna Ginalska z Zakładu Biochemii i Biotechnologii Uniwersytetu Medycznego w Lublinie.
Kompozyt bioaktywny to biomateriał uzupełniający ubytki kostne. Dzięki swoim właściwościom znajduje szerokie zastosowanie w zakresie stomatologii implantacyjnej, ortopedii czy też w przypadku urazów powstałych w wyniku mechanicznego uszczerbku, bądź chorób nowotworowych. Ze względu na jego plastyczność łatwo dostosowuje się do kształtu ubytku. Może być wykorzystywany jako nośnik leku, w tym antybiotyków i bez ryzyka pozostawać w ciele człowieka do końca życia. To ogromny postęp w dziedzinie chirurgii, który warto upowszechnić z myślą o pacjentach.
Realizacja działania umożliwiła komercjalizację wynalazku. W Polsce nie ma przedsiębiorstwa, które wytwarzałoby materiały kościozastępcze tego typu. To, co różni wynalazek prof. Grażyny Ginalskiej od alternatywnych materiałów produkowanych za granicą, to skład. W większości produktów wytwarzanych przez zagraniczne firmy obok fosforanu wapniowego są polimery białkowe (kolagen, fibryna) lub polimery syntetyczne. Opracowany kompozyt opracowany nie ma białka, ale cukier, dzięki temu jest bezpieczniejszy w zastosowaniu. Medical Inventi zamierza wprowadzić produkt na rynki globalne i skutecznie konkurować z potentatami w branży wyrobów medycznych.
- Nazwa Programu Operacyjnego: Inteligentny Rozwój
- Nazwa poddziałania: 2.3.2 Bony na innowacje dla MŚP
- Nazwa projektu: Zakup usługi polegającej na opracowaniu procesu technologicznego produkcji chronionego prawnie wynalazku o nazwie „Kompozyt bioaktywny oraz sposób wytwarzania kompozytu bioaktywnego” (decyzja Urzędu Patentowego Rzeczypospolitej Polskiej z dnia 5 marca 2010 r., kategoria i numer ochrony: WYN: (11) 206394), “Bioactive composite and process for the production of the bioactive composite” (European patent No 2421570 B1) w celu skonstruowania linii do jego produkcji
- Nazwa beneficjenta: Medical Inventi S.A.
- Wartość projektu: 489 749,10 zł
- Wartość dofinansowania: 318 560,00 zł